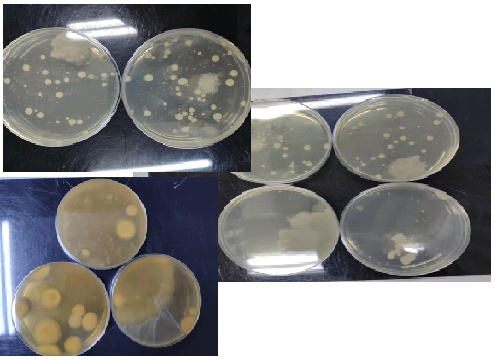

什么?键盘上也有微生物!
随着计算机的日益普及,人们在工作和生活中的大部分时间都是敲打着键盘度过的。

当我们享受着自己完成的
一份份精美的PPT汇报;
一件件繁琐的公文处理;
一次次刺激的游戏击杀,
你可曾想过自己的键盘上可能有无数看不见的微生物和你的指尖进行着亲密的交流。
接下来就是见证奇迹的时刻!

上海市疾控中心的小伙伴选了10个日常使用的电脑键盘,用浸有无菌生理盐水的棉拭子涂抹键盘表面的方法进行采样。

细菌和真菌菌落总数计数的平板(左)
致病菌检测使用的增菌培养液(右)
参照GB/T 18204.4-2013进行细菌、真菌菌落总数计数;大肠菌群、绿脓杆菌、金黄色葡萄球菌、溶血性链球菌等致病菌的检测。以GB37488-2019提及场所用品用具标准其他类用品细菌总数限值是300CFU/25cm²作为衡量标准。
部分菌落计数结果
最终抽检结果显示:10个键盘细菌菌落总数的中位数为4.78×10² CFU/25cm²(88-2.60×10³ CFU/25cm²);真菌菌落总数的中位数为30 CFU/件(0-85 CFU/件);1个键盘上检出金黄色葡萄球菌;大肠菌群、绿脓杆菌、溶血性链球菌均未检出。
注:CFU是指活菌培养计数中,由一个或多个生物体在固体培养基上生长繁殖形成的菌落称为菌落形成单位,表示活菌的数量。
样品 编号 | 细菌菌落
总数 (CFU/25cm²) | 真菌菌落
总数 (CFU/件) | 大肠菌群 | 绿脓杆菌 | 金黄色葡萄球菌 | 溶血
性链 球菌 |
| 1 | 1.33×10² | 10 | - | - | - | - |
| 2 | 8.80×10³ | 20 | - | - | - | - |
| 3 | 5.25×10² | 45 | - | - | + | - |
| 4 | 2.35×10³ | 85 | - | - | - | - |
| 5 | 4.10×10² | 35 | - | - | - | - |
| 6 | 2.60×10³ | 80 | - | - | - | - |
| 7 | 88 | 0 | - | - | - | - |
| 8 | 2.33×10² | 15 | - | - | + | - |
| 9 | 1.11×10³ | 60 | - | - | - | - |
| 10 | 4.30×10² | 25 | - | - | - | - |
结果显示:
键盘污染较为严重,还检测到1例金黄色葡萄球菌。金黄色葡萄球菌属人体常见的致病菌种类,一定条件下可造成消化道、呼吸道和皮肤等部位感染。
虽然这不是一项设计非常严谨的科学实验,但即便是随手一采样,也可以检测到这么多细菌,相信很多在用的键盘都有同样情况。
那我们应该怎么防止键盘污染对我们的健康造成影响呢?

01
定期清洁键盘
键盘的凹槽内容易堆积灰尘,建议清洁前先将键盘翻转拍打,或用毛刷、吹风机等清理灰尘。然后用酒精类消毒剂进行擦拭消毒。
02
保持良好手卫生习惯
养成及时洗手的好习惯,尽量减少对键盘的污染。同时在使用键盘的时候,不要吃东西,不要触摸皮肤、眼睛等粘膜部位造成感染。
清洁键盘的方法可参考:
办公室一族,请低头看看你键盘上的微生物乐园
上海市科委科普项目资助
项目编号:20DZ2312100
供 稿:陈泰尧
编 辑:刘雪薇
审 稿:张红芝 施烨闻 冯晓刚
